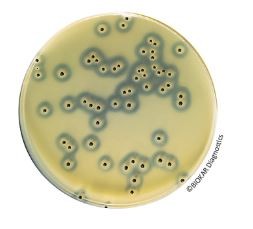
BAIRD PARKER Agar with Egg Yolk and Tellurite - Pre-poured medium

BAIRD PARKER Agar with Egg Yolk and Tellurite – 20 Petri plates 90 mm
$88.67
BAIRD-PARKER AGAR WITH EGG YOLK TELLURITE
ENUMERATION OF COAGULASE POSITIVE STAPHYLOCOCCI
Manufacturer:Biokar Diagnostics
Product Code:BM01808
- Description
- Size Guide
- Vendor Info
- More Products
Description
BAIRD PARKER Agar with Egg Yolk and Tellurite – 20 Petri plates 90 mm
BAIRD PARKER Agar with Egg Yolk and Tellurite – 20 Petri plates 90 mm
Product Decsription of Baird-Parker Agar with egg yolk and potassium tellurite is a selective medium for the detection and enumeration of Staphylococcus aureus in animal origin biological samples, pharmaceutical products, cosmetics, foods and water.
PACKAGING
Ready-to-use medium :
BM01808 – 20 Petri plates Ø 90 mm
BM09108 – 120 Petri plates Ø 90 mm
Dehydrated base medium (without egg yolk or tellurite) :
BK055HA – 500 g bottle
BK055GC – 5 kg drum
Sterile Egg yolk emulsion with Potassium tellurite :
BS06008 – 10 vials of 50 mL
BS03608 – 1 vial of 900 mL
Sulfamethazine 25 mg supplement :
BS02808 – 10 vials qsp 500 mL